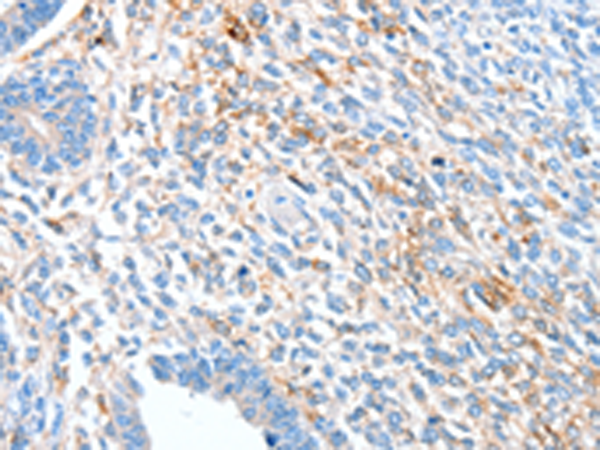

中文名稱:兔抗ALDH1A2多克隆抗體
英文名稱: Anti-ALDH1A2 rabbit polyclonal antibody
別 名: RALDH2; RALDH2-T; RALDH(II)
相關(guān)類別: 一抗
儲 存: 冷凍(-20℃)
宿 主: Rabbit
抗 原: ALDH1A2
反應(yīng)種屬: Human, Mouse, Rat
標 記 物: Unconjugate
技術(shù)規(guī)格
|
Background: |
This protein belongs to the aldehyde dehydrogenase family of proteins. The product of this gene is an enzyme that catalyzes the synthesis of retinoic acid (RA) from retinaldehyde. Retinoic acid, the active derivative of vitamin A (retinol), is a hormonal signaling molecule that functions in developing and adult tissues. The studies of a similar mouse gene suggest that this enzyme and the cytochrome CYP26A1, concurrently establish local embryonic retinoic acid levels which facilitate posterior organ development and prevent spina bifida. Four transcript variants encoding distinct isoforms have been identified for this gene. |
|
Applications: |
ELISA, WB, IHC |
|
Name of antibody: |
ALDH1A2 |
|
Immunogen: |
Synthetic peptide of human ALDH1A2 |
|
Full name: |
aldehyde dehydrogenase 1 family, member A2 |
|
Synonyms: |
RALDH2; RALDH2-T; RALDH(II) |
|
SwissProt: |
O94788 |
|
ELISA Recommended dilution: |
1000-5000 |
|
IHC positive control: |
Human ovarian cancer and Human colon cancer |
|
IHC Recommend dilution: |
25-100 |
|
WB Predicted band size: |
57 kDa |
|
WB Positive control: |
K562 cells |
|
WB Recommended dilution: |
500-2000 |

購物車
購物車 幫助
幫助
 021-54845833/15800441009
021-54845833/15800441009
